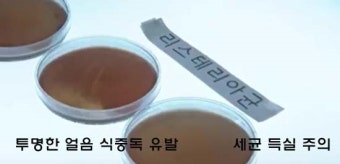

여름철 얼음 주의보, 얼음에서 세균이 득실, 얼름 틀, 식중독과 세균,예방 완벽 가이드
**여름철**이 되면 시원한 아이스 음료와 얼음의 소비가 급증합니다. 하지만, 집에서 얼음을 얼릴 때 얼음 틀 관리를 소홀히 하면 식중독과 세균 감염의 위험이 크게 높아집니다. 이 글에서는 여름철 얼음 주의보, 얼음 틀 세척법, 식중독 예방을 위한 핵심 정보를 키워드 중심으로 안내합니다.
예방 완벽 가이드 바로가기 링크



여름철 얼음, 왜 위험할까?
얼음 틀 세균 오염, 식중독 주범
**얼음 틀**은 깨끗한 물만 넣는다고 해서 안전하지 않습니다.**리스테리아균**과 노로바이러스 등 각종 식중독균이 얼음 틀에서 번식할 수 있습니다.
냉동실의 낮은 온도에서도 세균은 살아남을 수 있으며, 얼음이 녹는 과정에서 급격히 증식해 식중독을 유발할 수 있습니다.
실제로 여름철 얼음 소비가 늘면서 얼음 관련 식중독 사고가 빈번히 발생하고 있습니다.
얼음 틀, 반드시 이렇게 관리하세요
얼음 틀 세척·살균법
1. 얼음 틀, 사용할 때마다 꼼꼼히 세척
얼음을 꺼내고 새로 얼릴 때마다 반드시 얼음 틀을 세척하세요.
흐르는 물에 2분 이상 담갔다가 30초 이상 씻으면 노로바이러스와 리스테리아균 제거에 효과적입니다.
2. 끓인 물로 얼음 얼리기
끓인 물을 식혀서 얼음 틀에 부으면 세균 위험을 크게 줄일 수 있습니다.
수돗물이나 정수기 물보다 끓인 물이 위생적으로 더 안전합니다.
3. 주 1회 이상 살균 소독
**식초를 푼 물**에 얼음 틀을 20분간 담근 뒤 깨끗이 헹구고 말리면 살균 효과가 있습니다.
**쌀뜨물**에 1시간 담가두면 얼룩과 냄새 제거에 도움이 됩니다.
**굵은 소금**과 솔로 구석구석 문질러주면 묵은 때까지 제거할 수 있습니다.
여름철 얼음 식중독 예방 체크리스트

식중독 예방법, 얼음 안전 수칙
- 얼음 틀 세척: 매번 얼음 만들기 전후로 꼼꼼히 세척
- 끓인 물 사용: 가능하면 끓인 물로 얼음 만들기
- 손 위생 철저: 얼음이나 얼음 틀을 만지기 전후로 손 깨끗이 씻기
- 보관 온도 유지: 얼음, 음료, 식재료는 반드시 냉장·냉동 보관
- 장시간 방치 금지: 얼음이나 음료를 실온에 오래 두지 않기
- 텀블러·컵 세척: 얼음 음료를 담는 용기도 매일 세척
냉동실 얼음 저장 시 냄새 배임을 막는 방법
식품 밀폐 보관: 냉동실에 보관하는 모든 식품은 밀폐용기나 지퍼백에 넣어 보관해야 합니다.
음식 냄새가 퍼지는 것을 막아 얼음이 냄새를 흡수하는 것을 예방할 수 있습니다.
뚜껑 있는 얼음틀 또는 밀폐 용기 사용: 얼음을 만들 때 뚜껑이 있는 얼음틀이나,
얼음을 만든 후 밀폐 용기에 담아 보관하면 냉동실 내 냄새가 얼음에 배는 것을 줄일 수 있습니다.
얼음틀 정기 세척: 얼음틀은 사용할 때마다 중성세제나 쌀뜨물로 깨끗이 세척하고
완전히 건조시켜야 냄새와 세균 오염을 막을 수 있습니다.
쌀뜨물에 1시간 담가두면 플라스틱 냄새 제거에도 효과적입니다.
냉동실 내부 청소: 냉동실 선반과 벽면을 주기적으로 청소하고, 냉장고 내 탈취제를 사용하면 냄새가 줄어듭니다.
냉동실 내 탈취제 활용: 식빵, 숯, 베이킹소다, 오렌지 껍질 등을 냉동실에 두면 냄새 흡착에 도움이 됩니다.
이러한 방법을 실천하면 냉동실 얼음에 냄새가 배는 것을 효과적으로 예방할 수 있습니다.
여름철 얼음 주의보
- 얼음 틀 세척법
- 얼음 식중독
- 얼음 틀 세균
- 끓인 물 얼음
- 여름철 식중독 예방법
얼음 위생관리
여름철 얼음, 시원하게 즐기려면 위생이 우선입니다. 얼음 틀 세척과 끓인 물 사용, 식중독 예방 수칙을 꼭 지켜 건강한 여름 보내세요! 집에서 얼음을 자주 얼려 먹는 주부, 1인 가구, 건강에 민감한 소비자, 여름철 식중독 예방에 관심 있는 누구나
여름철 얼음, 안전하게 즐기세요!
얼음 틀 세척과 위생관리, 식중독 예방이 필수입니다.